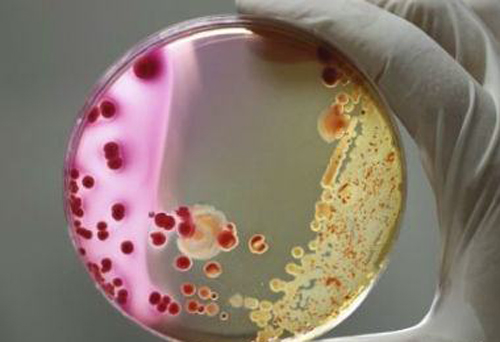

许建初团队:真菌“吃”掉塑料渣滓难题
已有人阅读此文 - -
1869年,外国人J.W.海厄特发觉在硝酸纤维素中添加樟脑丸和小量乙醇可做成一种延展性化学物质,压合下可成形为塑料产品,取名为赛璐珞。此后算起,塑料工业生产迄今已有120年的历史时间。 塑料给人们的日常生活产生了很多益处,他们便宜、轻巧、要用,早已变成当代生产制造日常生活无所不在的关键原材料。而且这种要求仍在持续提高,莱纳・麦克阿瑟慈善基金会“新塑料经济发展提倡”责任人罗伯・奥普索默先前在接纳新闻媒体访谈时表明,对塑料的要求到2030年很有可能也要翻一番。
但在享有塑料给日常日常生活产生的便捷的另外,塑料废弃物产生的环境污染问题也备受关注。大部分塑料都被垃圾填埋或进到海洋资源,而进到自然环境的塑料废料却给天然的动物与植物和生态体系产生了损害。
如何处理这种塑料废弃物,早已变成全世界世界各国一同关注的关键难题之一。
生物降解成网络热点
中科院昆明市植物研究所许建初精英团队近日公布,在塑料生物降解行业获得重大成果――发觉了塔宾曲霉菌对聚氨基甲酸酯的生物降解功效。此项科研成果以《塔宾曲霉菌(Aspergillustubingensis)对聚氨基甲酸酯的生物降解》问题,发布在国际性流行空气污染(Environmental Pollution)杂志期刊上。
在接纳《中国科学报》记者采访时,许建初表明,往往会挑选这一课题研究,恰好是看到了工业生产生成塑料的生产制造与应用早已对自然环境造成比较严重的伤害。他详细介绍说,聚氨基甲酸酯(PU)是一种新起的有机高分子原材料,也是当代塑料工业生产中发展更快的种类之一,普遍用以工业生产、诊疗、工程建筑和轿车等行业,被称作“第五大塑料”。大家日常日常生活普遍的泡沫塑料塑料、海棉和轿车软垫等,全是PU做成。
“全世界聚氨基甲酸酯(PU)总产量可能约为八百万吨(Mt),而且逐渐提升。这种不能降解的聚氨基甲酸酯废弃物造成 了土壤层和水质的环境污染,并最后进到深海生态体系。而传统式的垃圾填埋和焚烧处理占有很多土壤资源,危害土层构造及环境空气,非常容易导致二次绿色生态环境污染。”
专家费尽心思各种各样方法科学研究对pc聚碳酸酯的有机化学降解,现阶段pc聚碳酸酯的有机化学降解关键包含水解反应、热降解、光降解等,但这种降解成本增加且易造成二次污染。
为了更好地处理“白色垃圾”难题,使人类社会和地理环境可持续发展观,应用微生物方式降解塑料变成现如今的科学研究网络热点。
吃塑料的塔宾曲霉菌
在这以前,2016年,日本京东科技学院(Kyoto Institute of Technology)小田耕平(KoheiOda)研究组就曾报导发觉了一种非常有特质的解决塑料的微生物菌种,将其取名为Ideonellasakaiensis,该成效发布在《科学》杂志期刊上。
不论是以前小田耕平的科学研究,還是本次许建初精英团队的科学研究,基础对策大概类似:从塑料废弃物聚集的地区下手,发觉这些为此为食的“小宝贝”。
从坐落于塔吉克斯坦伊斯兰堡垃圾池集地域收集到整洁的土壤层试品后,将其放进杀菌盆里,与高纯聚氨酯材料(PU)塑料薄膜混和在一起,从而发觉了可以降解PU的塔宾曲霉菌。
许建初表述说,塔宾曲霉菌能够 在聚氨酯材料表层生长发育,并根据生长发育全过程中造成的酶和塑料产生微生物反映,毁坏塑料分子结构间或高聚物间的离子键;另外,这一细菌还运用了其真菌的物理学抗压强度,协助“掰开”塑料高聚物。在塔宾曲霉菌功效下,本来在地理环境中无法降解的塑料,两个星期就可以显著见到生物降解全过程,2个月后其培养液上的塑料高聚物基础消退。
与以前小田耕平精英团队的科学研究对比,二者全是有关微生物菌种生物降解有机化学塑料高聚物的科学研究,而且降解高效率相近。
但另外也存有下列三点不一样:最先塔宾曲霉菌是细菌,而Ideonellasakaiensis是病菌;次之所降解的塑料原材料不一样,许建初精英团队科学研究降解的是聚氨酯材料(PU),而小田耕平精英团队是聚对苯二甲酸乙二醇酯(PET);第三,Ideonellasakaiensis是初次发觉的刚种,由科学研究精英团队自身取名,而塔宾曲霉菌并并不是初次发觉及取名,确是初次发觉其有降解塑料的工作能力。
或成污染治理神器
谈起现阶段塑料生活垃圾处理的2个关键方位,许建初告知《中国科学报》新闻记者:一是发觉具有降解塑料废弃物工作能力的重要微生物菌种和重要酶,并营销推广至大规模生产;另一个是可生物降解的塑料的产品研发,关键根据汇聚木薯淀粉、二氧化碳等可降解小分子水来生产制造塑料产品。
“而在其中细菌溶解具有自身的与众不同优点。相较为别的传统式处理方法,细菌溶解可以彻底将高聚物降解成小分子水,占地面积少,不容易产生二次污染。而且其生产制造的小分子水化学物质可被别的植物体再次消化吸收运用。”
从早已发布的毕业论文介绍看出,科研成果早已在备受白色垃圾困惑的塔吉克斯坦北京首都伊斯兰堡进行了实际理论性的实验。许建初告知新闻记者,以现阶段的科学研究看来,塔宾曲霉菌具备宽阔的应用前景,“它归属于可塑造细菌,塑造标准并不严苛。而且降解速度迅速且实际效果显著,适用之后大规模生产。现阶段尚处在试验室小批量生产塑造环节,一旦掌握清晰在其中的体制原理,便可适用大批实验”。
在真实变成“污染治理神器”以前,许建初觉得,还必须处理下列四个关键难题:细菌的批量生产、塑料垃圾分类回收和前解决、细菌塑造标准的创建及其对在其中重要酶和体制的掌握。
许建初注重说:“细菌降解的塑料有其非特异,此外对塑料的成份构造很有可能也是有特殊的规定。除此之外,细菌降解塑料的工作能力受自然环境因素如溫度、ph酸碱度等的危害;而且在地理环境中,该全过程很有可能遭受别的微生物菌种的抑止。”
来源于:科学网

